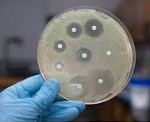

- Загальні відомості
- Етіологія і епідеміологія внутрішньолікарняних інфекцій
- Класифікація внутрішньолікарняних інфекцій
- Діагностика внутрішньолікарняних інфекцій
- Лікування внутрішньолікарняних інфекцій
- Профілактика внутрішньолікарняних інфекцій
Внутрішньолікарняних інфекцій - різні інфекційні захворювання, зараження якими відбулося в умовах лікувального закладу. Залежно від ступеня поширення розрізняють генералізовані (бактериемию, септицемію, септикопіємії, бактеріальний шок) і локалізовані форми внутрішньолікарняних інфекцій (з ураженням шкіри і підшкірної клітковини, дихальної, серцево-судинної, урогенітальної системи, кісток і суглобів, ЦНС і т. Д.) . Виявлення збудників внутрішньолікарняних інфекцій проводиться за допомогою методів лабораторної діагностики (мікроскопічних, мікробіологічних, серологічних, молекулярно-біологічних). При лікуванні внутрішньолікарняних інфекцій використовуються антибіотики, антисептики, імуностимулятори, фізіотерапія, екстракорпоральна гемокоррекция і т. Д.
Загальні відомості
Внутрішньолікарняні (госпітальні, нозокоміальних) інфекції - інфекційні захворювання різної етіології, що виникли у пацієнта або медичного працівника в зв'язку з перебуванням в лікувально-профілактичному закладі. Інфекція вважається внутрішньолікарняної, якщо вона розвинулася не раніше 48 годин після надходження хворого в стаціонар. Поширеність внутрішньолікарняних інфекцій (ВЛІ) в медичних установах різного профілю становить 5-12%. Найбільшу питому вагу внутрішньолікарняних інфекцій припадає на акушерські та хірургічні стаціонари (відділення реанімації, абдомінальної хірургії, травматології , Опікової травми, урології , гінекології , отоларингології , Стоматології, онкології і ін.). Внутрішньолікарняних інфекцій є великою медико-соціальну проблему, оскільки обтяжують перебіг основного захворювання, збільшують тривалість лікування в 1,5 рази, а кількість летальних результатів - в 5 разів.
внутрішньолікарняних інфекцій
Етіологія і епідеміологія внутрішньолікарняних інфекцій
Основними збудниками внутрішньолікарняних інфекцій (85% від загального числа) виступають умовно-патогенні мікроорганізми: коки (епідермальний і золотистий стафілокок, бета-гемолітичний стрептокок , Пневмокок, ентерокок) і грамнегативні паличкоподібні бактерії (клебсієли, ешерихії, ентеробактерій, протей, псевдомонади та ін.). Крім цього, в етіології внутрішньолікарняних інфекцій велика питома роль вірусних збудників простого герпесу , аденовірусної інфекції , грипу , Парагрипу, цитомегалии , вірусних гепатитів , респіраторно-синцитіальних інфекції , а також риновірусів , Ротавірусів, ентеровірусів та ін. Також внутрішньолікарняні інфекції можуть бути викликані умовно-патогенними і патогенними грибами (дріжджоподібними, пліснявими, променистими). Особливістю внутрішньогоспітальних штамів умовно-патогенних мікроорганізмів служить їх висока мінливість, лікарська резистентність і стійкість до впливу чинників середовища (ультрафіолету, дезінфектантів та ін.).
Джерелами внутрішньолікарняних інфекцій в більшості випадків виступають пацієнти або медичний персонал, що є бактеріоносіями або хворими стертими і маніфестних формами патології. Як показують дослідження, роль третіх осіб (зокрема, відвідувачів стаціонарів) в поширенні ВЛІ невелика. Передача різних форм госпітальної інфекції реалізується за допомогою повітряно-краплинного, фекально-орального, контактного, трансмиссивного механізму. Крім цього, можливий парентеральний шлях передачі внутрішньолікарняної інфекції при проведенні різних інвазивних медичних маніпуляцій: забору крові, ін'єкцій, вакцинації , Інструментальних маніпуляцій, операцій, ШВЛ , гемодіалізу та ін. Таким чином в медустанові можливо заразитися гепатитами В , З і D , Гнійно-запальними захворюваннями, сифілісом , ВІЛ-інфекцією . Відомі випадки внутрішньолікарняних спалахів легіонельозу при прийомі хворими лікувальних душів і вихрових ванн.
Факторами, які беруть участь в поширенні внутрішньолікарняної інфекції, можуть виступати контаміновані предмети догляду та обстановки, медичний інструментарій та апаратура, розчини для інфузійної терапії, спецодяг і руки медперсоналу, вироби медичного призначення багаторазового використання (зонди, катетери, ендоскопи), питна вода, постільні приналежності, шовний та перев'язочний матеріал і мн. ін.
Значимість тих чи інших видів внутрішньолікарняної інфекції багато в чому залежить від профілю лікувального закладу. Так, в опікових відділеннях переважає синьогнійна інфекція , Яка в основному передається через предмети догляду та руки персоналу, а головним джерелом внутрішньолікарняної інфекції є самі пацієнти. В установах допомоги породіллі основну проблему представляє стафілококова інфекція, яка поширюється медичним персоналом-носієм золотистого стафілокока. В урологічних відділеннях домінує інфекція, що викликається грамнегативною флорою: кишковою, синьогнійної палички та ін. В педіатричних стаціонарах особливу значимість має проблема поширення дитячих інфекцій - вітряної віспи , епідемічного паротиту , краснухи , кору . Виникненню і поширенню внутрішньолікарняної інфекції сприяють порушення санітарно-епідеміологічного режиму ЛПУ (недотримання особистої гігієни, асептики і антисептики, режиму дезінфекції та стерилізації, несвоєчасне виявлення та ізоляція осіб-джерел інфекції і т. Д.).
До групи ризику, в найбільшою мірою схильною до розвитку внутрішньолікарняної інфекції, ставляться новонароджені (особливо недоношені ) І діти раннього віку; літні та ослаблені пацієнти; особи, які страждають хронічними захворюваннями ( на цукровий діабет , Хворобами крові, нирковою недостатністю ), Імунодефіцитом, онкопатологією. Сприйнятливість людини до внутрішньолікарняних інфекцій збільшується при наявності у нього відкритих ран, порожнинних дренажів, внутрішньосудинних і сечових катетерів, трахеостоми та інших інвазивних пристроїв. На частоту виникнення і тяжкість перебігу внутрішньолікарняної інфекції впливає довге перебування пацієнта в стаціонарі, тривала антибіотикотерапія, імуносупресивної терапії.
Класифікація внутрішньолікарняних інфекцій
За тривалістю перебігу внутрішньолікарняні інфекції діляться на гострі, підгострі і хронічні; по тяжкості клінічних проявів - на легкі, середньотяжкі і важкі форми. Залежно від ступеня поширеності інфекційного процесу розрізняють генералізовані і локалізовані форми внутрішньолікарняної інфекції. Генералізовані інфекції представлені бактериемией, септицемією, бактеріальним шоком. У свою чергу, серед локалізованих форм виділяють:
- інфекції шкіри, слизових і підшкірної клітковини, в т. ч. післяопераційних, опікових, травматичних ран. Зокрема, до їх числа відносяться омфаліт , абсцеси і флегмони , пиодермия , рожа , мастит , парапроктит , грибкові інфекції шкіри та ін.
- інфекції порожнини рота ( стоматит ) І ЛОР-органів ( ангіна , фарингіт , ларингіт , епіглоттіт , риніт , синусит , отит , мастоидит )
- інфекції бронхолегеневої системи ( бронхіт , пневмонія , плеврит , абсцес легені , гангрена легкого , емпієма плеври , медиастинит )
- інфекції травної системи ( гастрит , ентерит , коліт , Вірусні гепатити)
- очні інфекції ( блефарит , кон'юнктивіт , кератит )
- інфекції урогенітального тракту (бактеріурія, уретрит , цистит , пієлонефрит , Ендометрит, аднексит )
- інфекції кістково-суглобової системи ( бурсит , артрит , остеомієліт )
- інфекції серця і судин ( перикардит , міокардит , ендокардит , тромбофлебіти ).
- інфекції ЦНС ( абсцес мозку , менінгіт , мієліт та ін.).
У структурі внутрішньолікарняних інфекцій на частку гнійно-септичних захворювань припадає 75-80%, кишкових інфекцій - 8-12%, гемоконтактних інфекцій - 6-7%. На інші інфекційні захворювання (ротавірусна інфекції, дифтерію , туберкульоз , Мікози та ін.) Припадає близько 5-6%.
Діагностика внутрішньолікарняних інфекцій
Критеріями, що дозволяють думати про розвиток внутрішньолікарняної інфекції, служать: виникнення клінічних ознак захворювання не раніше ніж через 48 годин після надходження в стаціонар; зв'язок з проведенням інвазивного втручання; встановлення джерела інфекції та фактора передачі. Остаточне судження про характер інфекційного процесу отримують після ідентифікації штаму збудника за допомогою лабораторних методів діагностики.
Для виключення або підтвердження бактеріємії проводиться бактеріологічний посів крові на стерильність, бажано не менше 2-3-х разів. При локалізованих формах внутрішньолікарняної інфекції мікробіологічне виділення збудника може бути вироблено з інших біологічних середовищ, в зв'язку з чим виконується посів сечі, калу, харкотиння, виділень ран, матеріалу із зіву, мазка з кон'юнктиви, з статевих шляхів на мікрофлору. Додатково до культуральному методу виявлення збудників внутрішньолікарняних інфекцій використовуються мікроскопія, серологічні реакції (РСК, РА, ІФА, РІА), вірусологічний, молекулярно-біологічний (ПЦР) методи.
Лікування внутрішньолікарняних інфекцій
Складнощі лікування внутрішньолікарняної інфекції обумовлені її розвитком в ослабленому організмі, на тлі основної патології, а також резистентністю госпітальних штамів до традиційної фармакотерапії. Хворі з діагностованими інфекційними процесами підлягають ізоляції; у відділенні проводиться ретельна поточна і заключна дезінфекція. Вибір протимікробної препарату грунтується на особливостях антибіотикограми: при внутрішньолікарняної інфекції, викликаної грамположительной флорою найбільш ефективний ванкоміцин; грамнегативними мікроорганізмами - карбапенеми, цефалоспорини IV покоління, аміноглікозиди. Можливо додаткове застосування специфічних бактеріофагів, імуностимуляторів, інтерферону, лейкоцитарної маси, вітамінотерапії.
При необхідності проводиться чрескожное опромінення крові (ВЛОК, УФОК ), Екстракорпоральна гемокоррекция ( гемосорбция , Лимфосорбция). Симптоматична терапія здійснюється з урахуванням клінічної форми внутрішньолікарняної інфекції за участю фахівців відповідного профілю: хірургів , травматологів , Пульмонологів, урологів, гінекологів та ін.
Профілактика внутрішньолікарняних інфекцій
Основні заходи профілактики внутрішньолікарняних інфекцій зводяться до дотримання санітарно-гігієнічних і протиепідемічних вимог. В першу чергу, це стосується режиму дезінфекції приміщень і предметів догляду, застосування сучасних високоефективних антисептиків, проведення якісної предстерилизационной обробки і стерилізації інструментарію, неухильне дотримання правил асептики і антисептики.
Медичний персонал повинен дотримуватись заходів індивідуального захисту при проведенні інвазивних процедур: працювати в гумових рукавичках, захисних окулярах і масці; обережно поводитися з медичним інструментарієм. Велике значення в профілактиці внутрішньолікарняних інфекцій має вакцинація медпрацівників від гепатиту В, краснухи, грипу, дифтерії, правця та інших інфекцій. Всі співробітники ЛПУ підлягають регулярному плановому диспансерному обстеження, спрямованого на виявлення носійства патогенів. Попередити виникнення і поширення внутрішньолікарняних інфекцій дозволить скорочення термінів госпіталізації пацієнтів, раціональна антибіотикотерапія, обгрунтованість проведення інвазивних діагностичних та лікувальних процедур, епідеміологічний контроль в ЛПЗ.













